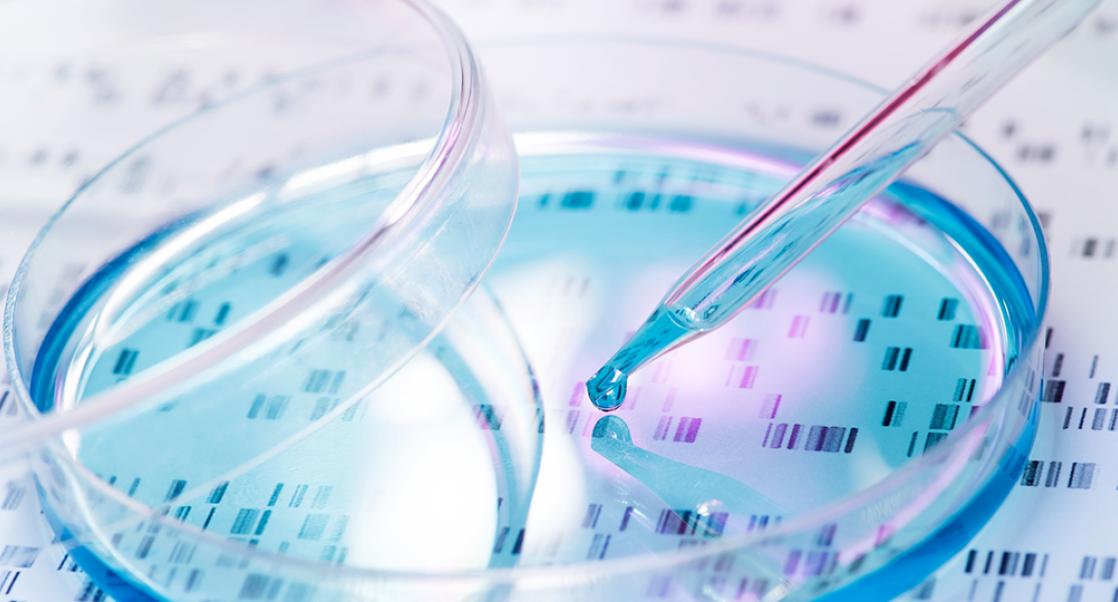
DNA Sequencing Saves the Day

Biologics
|
Matt Hewitt
Decentralized Manufacturing: Cell Therapy’s Next Evolution
How to ensure cell therapies don’t get trapped in manufacturing and/or logistical bottlenecks
Cell and gene therapies are proven game changers for the field of biologics. Market analysts differ slightly on how fast the market will grow, but all predict significant expansion. While the US Food and Drug Administration has approved seven cell and gene therapies in the past 4 years (with cilta-cel likely following with a PDUFA date at the end of November), the cell and gene therapy product pipeline is teeming with approximately 1,200 experimental therapies, more than half in Phase 2 clinical trials, notes Chemical and Engineering News .
The trend is toward decentralized manufacturing
Given the field is already experiencing difficulties, primarily in manufacturing, it should surprise no one that the “next big thing” on the horizon which will alter the pharma/biopharma landscape and change the way therapeutic developers and their partners do business is decentralized manufacturing. In fact, this approach is poised to become the dominant method for commercial cell therapy manufacturing for oncology and auto-immunity. Here’s why.
Shipping cell therapies requires ultra-cold chain logistics (below -150 °C) with complex interactions. The current model has enabled the field to show we can commercialize cell therapies for relatively small patient populations. But, the currently approved cell therapies, outside the multiple myeloma therapy Abecma, address relatively small hematological oncology indications; only a few thousand patients worldwide are treated per year.
Even treating relatively small patient populations comes with bottlenecks because the manufacturing occurs in different regions. A recent European Hematology Association (EHA) poster from Sheba Medical Center in Israel detailed some of these issues (EHA 2021 Abstract #EP526). In the poster, lead author Dr. Shalev Fried examined Kymriah’s performance across 37 diffuse large B-cell lymphoma (DLBCL) patients. Of the 37 apheresed, only 28 (76%) were manufactured successfully while the other 9 (24%) failed manufacturing and products were deemed out-of-specification (OOS) by failing to meet the preset product release criteria (i.e. minimum cell number). Of the 9 OOS products, only 3 were dosed leaving 6 patients (16%) who received no therapy. Fortunately, the 6 patients were able to have their cells manufactured on-site using Sheba’s manufacturing process (decentralized fashion).
As additional cell therapies are approved some will be positioned to serve larger patient populations. When this happens, the current centralized manufacturing model will become stressed and likely untenable.
A present example of this can be found with the cell therapies approved or imminently approved for multiple myeloma. Between North American and Europe, there are approximately 85,000 patients diagnosed with multiple myeloma and 34,000 deaths per year. This represents a significantly larger addressable patient population than other current approved therapies. Developers are finding that demand is outstripping supply, and limited vector availability. One company has, for the moment, only one manufacturing facility to meet their global needs. Companies have committed to a 28-day vein-to-vein turnaround time—the time between patient starting material collection to cell product infusion back to the patient—but whether this is sustainable when demand grows remains to be seen.
Partnering with CDMOs is key
With additional cell therapy approvals, another pain-point will be staffing GMP manufacturing facilities. As such, it does not make sense for each CGT company to build out their own manufacturing capabilities given an already fierce war on talent, which will continue to drive up manufacturing costs.
Navigating this challenge is critical and one solution includes industry partnering with CDMOs like Charles River to build a hub-and-spoke decentralized, multi-modal (multi-therapy) manufacturing network to maximize utilization and lower therapeutics costs. Collaborative work to build this structure will allow us to stratify the workforce and better utilize people, which, let’s face it, are a finite resource.
There will be challenges with this decentralized model, one likely being supply logistics. Yet as the field migrates toward manufacturing using closed, automated, scalable platforms this will become easier because only certain kitted manufacturing disposables will be required.
This is an occasional series on trends in cell and gene therapies. Stay tuned for Matt’s next post about the exciting movement toward cell therapies for autoimmune disorders.

Cell Therapy Manufacturing Services
Our comprehensive package of autologous and allogeneic cell therapy manufacturing services includes GMP production of cells from preclinical to commercial applications from a variety of starting materials. As an experienced CDMO, we can swiftly scale-up and support production from clinical to commercial manufacturing.